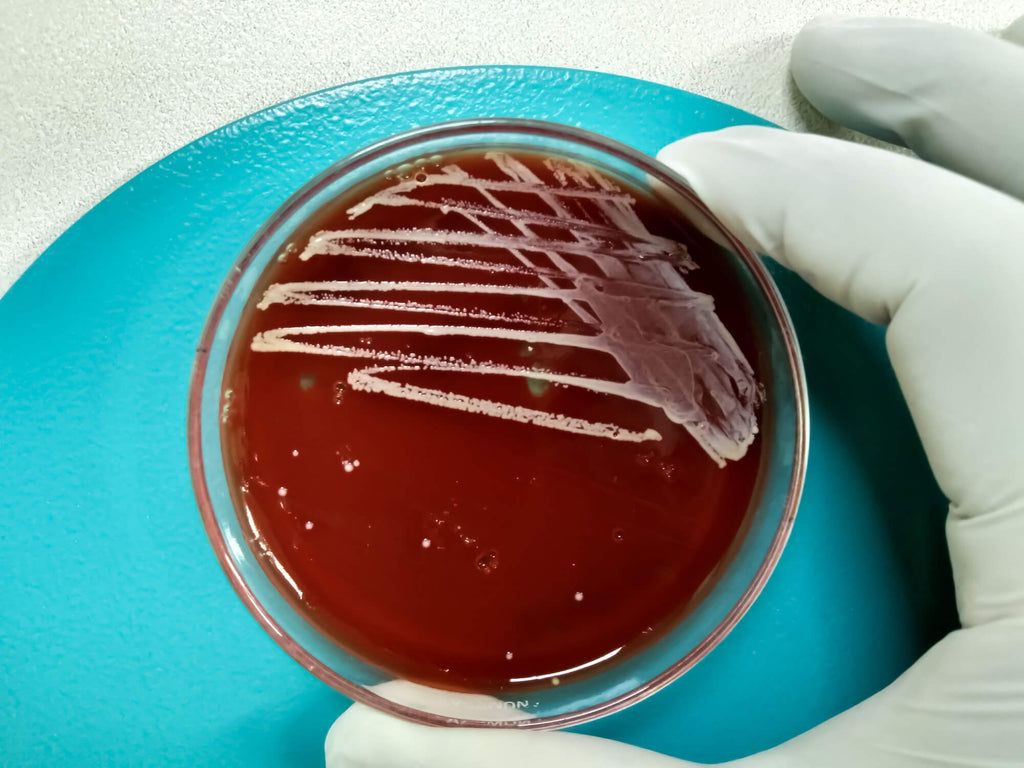
Enterococcus faecium - Dog Probiotic

When it comes to bolstering the health of our canine companions, understanding the role of dog probiotics is crucial. Not all probiotics are created equal, and certain strains hold unique benefits for your furry friend. In this article, we delve into the world of beneficial bacteria, highlighting five key strains that are particularly beneficial for dogs. These strains can make a significant difference in various aspects of canine health, from enhancing gut function to boosting immunity. Let’s explore these microscopic heroes and how they contribute to a happier, healthier life for your dog.
Wait, What Are Probiotics?
Probiotics are often described as 'good' or 'beneficial' bacteria – they are live microorganisms that, when consumed in adequate amounts, provide numerous health benefits, particularly for the digestive system. Found naturally in both the human and canine gut, these bacteria play a vital role in maintaining a healthy balance of gut flora. This balance is essential for proper digestion, nutrient absorption, and a robust immune system. Probiotics are similar to the naturally occurring beneficial bacteria in the gut and can be supplemented to enhance a dog's overall health.
Why Does My Dog Need Probiotics?
Probiotics are crucial for maintaining your dog's gut health, which is a significant determinant of their overall well-being. Dogs, like humans, can experience imbalances in gut flora due to factors like diet changes, stress, age, and medication. Such imbalances can lead to digestive issues, weakened immune responses, and even behavioural changes. Supplementing your dog's diet with probiotics helps restore and maintain a healthy gut flora balance, promoting better digestive health, boosting the immune system, and potentially improving mood and behaviour. Essentially, probiotics for dogs are a key component in ensuring they lead a healthy, happy life.

1. Saccharomyces boulardii: A Probiotic Powerhouse for Digestive Resilience
Saccharomyces boulardii, unique as a probiotic yeast, is a game-changer in managing canine digestive health. This resilient strain stands up to gastric acidity, ensuring it reaches the gut where it’s most needed. Its forte lies in battling diarrhoea, a common canine affliction, by fortifying the gut lining and preventing harmful bacterial intrusion. This not only aids in rapid recovery from digestive upsets but also maintains intestinal integrity.
What’s more, Saccharomyces boulardii is a champion in nutrient absorption. It assists dogs in getting the maximum benefit from their meals, crucial for those with sensitive stomachs or recovering from gastrointestinal issues. Its role becomes even more critical during antibiotic treatments, often known to throw gut flora off balance. Supplementing with this probiotic can counteract such disruptions, safeguarding your dog’s gut health.
Introducing Saccharomyces boulardii through high-quality supplements can significantly boost your dog’s digestive resilience. However, it’s essential to consult a veterinarian for the right dosage and approach, especially for dogs with specific health concerns. This remarkable yeast-based probiotic is more than just a supplement; it’s a key player in nurturing your dog’s digestive wellbeing.
Saccharomyces boulardii is the main probiotic found in our daily Probiotic Gut Health Chews.

2. Lactobacillus acidophilus: Strengthening Canine Digestive Health
Lactobacillus acidophilus, a prominent probiotic strain, stands out for its remarkable impact on canine digestive health. This friendly bacterium, naturally residing in the dog's gut, plays a critical role in the digestive process. It aids in breaking down food, ensuring efficient nutrient absorption, and establishing a hostile environment for pathogenic bacteria. Regular intake of Lactobacillus acidophilus can significantly alleviate common digestive disturbances in dogs, such as diarrhoea, bloating, and excessive gas.
Beyond just aiding digestion, this probiotic strain also contributes to the overall quality of the gut environment. By maintaining an optimal pH balance in the intestines, Lactobacillus acidophilus helps create conditions that favour the growth of beneficial bacteria while inhibiting harmful ones. This balance is vital for gut health, as it prevents the overgrowth of pathogenic bacteria that can lead to gastrointestinal illnesses.
Furthermore, Lactobacillus acidophilus has been found to enhance the immune function of the gut. It stimulates the production of antibodies and supports the intestinal barrier against potential pathogens, reducing the likelihood of infections and boosting the dog's overall immunity. This aspect is particularly beneficial for dogs with weakened immune systems or those recovering from illness.
Incorporating this probiotic into a dog's diet can be done through specific supplements or by choosing dog foods fortified with Lactobacillus acidophilus. For pet owners who prefer natural sources, fermented foods like kefir or specific types of dog-safe yoghurt can be good options. However, it's essential to ensure these are given in appropriate amounts and are free from ingredients harmful to dogs, such as xylitol, a common sweetener in human foods.
3. Bifidobacterium animalis: A Cornerstone for Canine Immunity
Bifidobacterium animalis is a probiotic strain that plays a pivotal role in the immune health of dogs. Renowned for its capacity to enhance the body's defence mechanisms, this probiotic is integral in maintaining a robust immune system. Its presence in the gut is closely linked to an improved response against pathogens, making dogs more resilient to infections and diseases.
This strain is particularly effective in modulating the immune system. By stimulating the production of immune cells and antibodies, Bifidobacterium animalis enhances the body's ability to fight off invading microorganisms. It acts as a natural immune booster, which is especially beneficial for puppies whose immune systems are still developing, as well as older dogs who may have weakened immunity due to age.
In addition to its direct immune-boosting properties, Bifidobacterium animalis also contributes to gut health, which is intrinsically linked to the overall immune function. A healthy gut is essential for proper nutrient absorption and elimination of waste and toxins. By promoting a balanced gut microbiome, this probiotic helps ensure that the digestive system functions smoothly, indirectly supporting the immune system.
For dogs with a history of allergies or autoimmune issues, Bifidobacterium animalis can be particularly beneficial. Its ability to balance the immune response can help alleviate overreactions to allergens, providing relief from allergy symptoms and improving the dog's quality of life.
Incorporating Bifidobacterium animalis into a dog's diet can be achieved through specifically formulated probiotic supplements or through certain probiotic-enriched dog foods. As with any dietary change, it's recommended to consult with a veterinarian to determine the appropriate probiotic formulation and dosage, especially for dogs with specific health concerns or dietary restrictions.
4. Enterococcus faecium: A Keystone in Canine Gut Ecosystem
Enterococcus faecium, a resilient probiotic strain, plays a pivotal role in the intricate ecosystem of the canine gut. This robust bacterium is adept at thriving in the challenging intestinal environment, where it becomes instrumental in preserving and restoring the delicate balance of the gut microbiota. Particularly during and post-antibiotic treatments, when the equilibrium of gut flora is disrupted,



